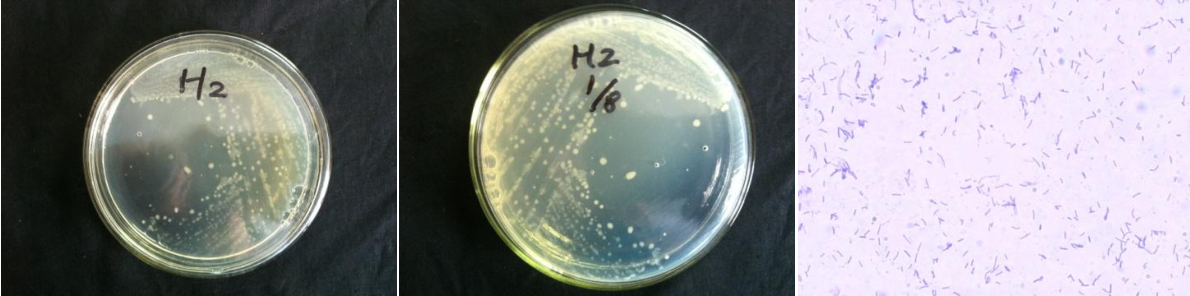

Loading...
| StrainNO | B488 |
| Classification | Paenibacillus |
| 16s rDNA sequence | TACAAGACCCGGGAACGTATTCACCGCGGCATGCTGATCCGCGATTACTAGCAATTCCGACTTCATGCAGGCGAGTTGCAGCCTG CAATCCGAACTGAGACTGGCTTTTATAGGATTGGCTCCACCTCGCGGCTTCGCTTCCCGTTGTACCAGCCATTGTAGTACGTGTG TAGCCCAAGTCATAAGGGGCATGATGATTTGACGTCATCCCCGCCTTCCTCCGGTTTGTCACCGGCAGTCATTCTAGAGTGCCCA CCATCATGTGCTGGCAACTAAAATCAAGGGTTGCGCTCGTTGCGGGACTTAACCCAACATCTCACGACACGAGCTGACGACAACC ATGCACCACCTGTCACCTCTGTCCCGAAGGCCGCCTCTATCTCTAGAGGATTCAGAGGGATGTCAAGACTTGGTAAGGTTCTTCG CGTTGCTTCGAATTAAACCACATACTCCACTGCTTGTGCGGGTCCCCGTCAATTCCTTTGAGTTTCAGTCTTGCGACCGTACTCC CCAGGCGGAATGCTTAATGTGTTAACTTCGGCACCAAGGGTATCGAAACCCCTAACACCTAGCATTCATCGTTTACGGCGTGGAC TACCAGGGTATCTAATCCTGTTTGCTCCCCACGCTTTCGCGCCTCAGCGTCAGTTACAGCCCAGAGAGTCGCCTTCGCCACTGGT GTTCCTCCACATATCTACGCATTTCACCGCTACACGTGGAATTCCACTCTCCTCTTCTGCACTCAAGTCCCCCAGTTTCCAGTGC GACCCGAAGTTGAGCCTCGGGTTTAAACACCAGACTTAAAGAACCGCCTGCGCGCGCTTTACGCCCAATAATTCCGGACAACGCT TGCCCCCTACGTATTACCGCGGCTGCTGGCACGTAGTTAGCCGGGGCTTTCTTCTCAAGTACCGTCACTCTCCTAGCAGTTACTC TAGAAGACGTTCTTCCTTGGCAACAGAGCTTTACGATCCGAAAACCTTCATCACTCACGCGGCGTTGCTCCGTCAGGCTTTCGCC CATTGCGGAAGATTCCCTACTGCTGCCTCCCGTAGGAGTCTGGGCCGTGTCTCAGTCCCAGTGTGGCCGTTCACCCTCTCAGGTC GGCTACGCATCGTCGCCTTGGTGAGCCGTTACCCCACCAACTAGCTAATGCGCCGCAGGCCCATCCCCAAGTGACAGATTGCTCC GTCTTTCATTATTCCACAATGCTGTGAAATAAATTATCCGGTATTAGCTACCGTTTCCGGTAGTTATCCCAGTCTTGAGGGCAGG |
| Strain Morphology Photos | |
| Morphological Description | Colony round;Lychee flesh white;edge neatly;Flattened;slippy;sticky:Rod;no spore |